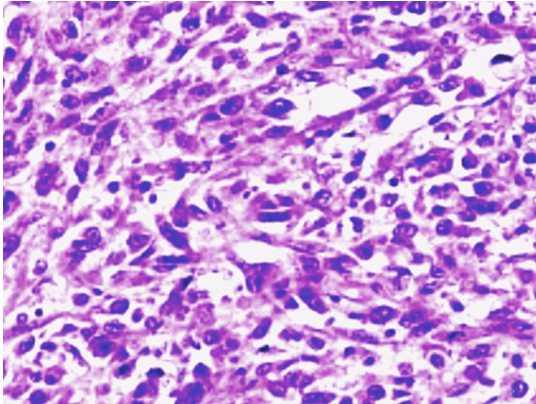

| Table of Contents |  |
|
Case Series
| |||||
| Pure non-bilharzial squamous cell carcinoma: An unusual form of carcinoma of the bladder | |||||
| Fatima Safini1, Hassan Jouhadi2, Meriem Elbachiri1, Souha Sahraoui2, Abdellatif Benider3 | |||||
|
1Doctor, Department of Oncology and Radiotherapy, Mohammed VI Cancer Treatment Center, IbnRochd University Hospital, Casablanca, Morocco.
2Associate professor, Department of Oncology and Radiotherapy, Mohammed VI Cancer Treatment Center, IbnRochd University Hospital, Casablanca, Morocco. 3chef of the Department of Oncology and Radiotherapy, Mohammed VI Cancer Treatment Center, IbnRochd University Hospital, Casablanca, Morocco. | |||||
| |||||
|
[HTML Abstract]
[PDF Full Text]
[Print This Article]
[Similar article in Pumed] [Similar article in Google Scholar] |
| How to cite this article: |
| Safini F, Jouhadi H, Elbachiri M, Sahraoui S, Benider A. Pure non-bilharzial squamous cell carcinoma: An unusual form of carcinoma of the bladder. J Case Rep Images Surg 2016;2:31–35. |
|
Abstract
|
|
Introduction:
Non-bilharzial squamous cell carcinoma (NBSCC) is an uncommon form of bladder cancer. In spite of the therapeutic progress, this malignancy is still aggressive with poor prognosis. We systematically reviewed our experience with squamous cell carcinoma of bladder within a period of five years.
Case Series: We performed a retrospective study on seven patients with pure NBSCC of the bladder treated at our radiotherapy and oncology department from 2008 to 2012. A male predominance was observed. The average age at diagnosis was 58 years. The average consultation time was one year. The reason for consultation was hematuria among the seven patients. All of them underwent cystoscopy with biopsy. All the cases displayed muscle invasive carcinoma with a staging of at least T3. Radical cystectomy was the chosen treatment in three cases. Adjuvant treatment was conducted for three patients by receiving either postoperative local irradiation or chemotherapy. Two patients had received an exclusive combined radio-chemotherapy (cisplatin and pelvic irradiation of 60 Gy). Two patients had received palliative care. Conclusion: Our data show the individuality and poor prognosis of squamous cell cancerous lesions of the urinary tract. The optimal treatment of pure NBSCC of the bladder is not conclusively codified. Further studies are fundamentally in order to optimize the treatment of patients with this rare urological tumor entity. | |
|
Keywords:
Bladder cancer, Non-bilharzial, Squamous cell carcinoma
| |
|
Introduction
| ||||||
|
Non-bilharzial squamous cell carcinoma is the most prevalent epithelial neoplasm of the bladder after urothelial carcinoma, accounting approximately for 3–5% of bladder tumors in Western countries [1]. It is associated with chronic irritation of the bladder. In contrast to transitional cell carcinoma, NBSCC of the bladder is characterized by a lower frequency of distant metastases. The patients die usually after locoregional recurrence [1][2][3]. Due to the rarity of this entity, prospective studies are necessary to codify the optimal management of this disease. In the present study, we retrospectively reviewed our experience with non-bilharzial squamous cell carcinoma of bladder within a period of five years. | ||||||
|
Case Series
| ||||||
|
A retrospective study was conducted in radiotherapy and oncology department of Ibn Rochd hospital during a five-year study period between January 2008 and December 2012. Diagnosis was established on biopsy in all the patients. Staging was performed on the basis of the TNM criteria. None of the patients suffered from schistosomiasis. We included only pure NBSCC. For the identified cases, clinical history, treatment, histology, and postoperative follow-up were recorded. Each patient had a preoperative metastatic workup that included blood tests, computed tomography (CT) scan of the chest, abdomen and pelvis, and bone scan. Between January 2008 and December 2012, seven cases of NBSCC of the bladder were diagnosed on endoscopic biopsy specimen out of 935 patients with bladder cancer with frequency of 1.7%. The characteristics of our patients are summarized in Table 1. The age range was between 40 and 76 years and the average age at diagnosis was 58 years. In our collective, a male predominance was observed including five males and two females. The duration of symptoms ranged from six months to two years and the average time of consultation was one year. Among the patients presented with hematuria, there were four patients who suffered from pelvic pain and three patients had urinary frequency and urinary discharge. Five patients reported significant weight loss. All the patients underwent cystoscopy with biopsy and resection. The diagnosis was carried out at an advanced stage in all patients. Two patients had distant metastasis at presentation. One patient had pulmonary metastasis and the other patient had bone metastasis. Three patients had pelvic lymph node involvement. Radical cystectomy was the chosen treatment in three cases. Adjuvant chemotherapy was administered in the three patients using gemcitabine/cisplatine in two cases and methotrexate/cisplatin in one case. Two patients inoperable had received an exclusive combined radio-chemotherapy with cisplatin weekly and pelvic irradiation of 60 Gy. The other two patients had received best supportive care. With a median follow-up period of 25 months, three patients had died from NBSCC of the bladder, two of them were metastatic. Three other patients had local recurrence, two of them were treated by chemoradiation and just one patient was treated by surgery. | ||||||
| ||||||
| ||||||
| ||||||
| ||||||
|
| ||||||
| ||||||
|
Discussion
| ||||||
|
Non-bilharzial SCC and bilharzial SCC of the bladder are two entities that differ in incidence, epidemiology, and natural history [1]. The risk factors of non-schistosoma related squamous cell carcinoma are various. The most relevant common factor appears to be some form of chronic bladder irritation. This condition occur in patients with chronic inflammatory disorders of the bladder, persistent calculi, chronic cystitis, and bladder diverticula, cyclophosphamide treatment, intravesical Bacillus Calmette-Guérin (BCG). In the United States, patients with spinal cord injury represent the largest group of patients affected by NBSCC. The black race is also considered a risk factor for some authors [2] [3]. The relation between SCC and smoking is not clear [2] [3]. Pure SCC of the bladder must be distinguished from urothelial carcinoma with squamous differentiation. In our study, we included only pure NBSCC of the bladder. Superficial tumors are almost never seen; because most of patients present with locally advanced disease. Clinical presentation and tumor location are similar to the other histological gender. Treatment of NBSCC of the bladder has been controversial, because patients are usually given the diagnosis of NBSCC at an advanced stage. Options include surgical resection, chemotherapy and radiotherapy [1]. Radical cystectomy remains the mainstay of therapy for pure NBSCC of the bladder [4]. The role of radical cystectomy as the key therapeutic approach for bladder SCC has been previously shown by Richie et al., who documented a five-year survival of 48% among patients treated with cystectomy and lymphadenectomy [5]. Current data on the therapeutic results after external irradiation are poor. Radiotherapy has been used exclusively or as an adjunct to surgery in the neoadjuvant setting [1] [6]. Neo-adjuvant irradiation has been discussed by several authors and small patient series, which reports that patients who were downstaged by neoadjuvant radiation therapy demonstrated durable response to therapy. These results were not confirmed by prospective studies, and the benefit of preoperative radiation to improve local control is still uncertain [7]. We can not assess the impact of this therapeutic approach because none of our patients had received neoadjuvant radiotherapy. Systemic chemotherapy is not very effective to date because NBSCC is described as a chemotherapy refractory disease and is considerably less responsive to standard chemotherapy regimens used for urothelial carcinoma. The standard chemotherapy regimens seem to have limited impact on the disease because of the relative chemo-resistance of NBSCC [8]. An effective chemotherapy protocol against this disease has not yet been found; however, new protocols using "Gemcitabine - cisplatin" may offer better responses [8] [9]. The role of neoadjuvant or adjuvant chemotherapy in the treatment of patients with pure SCC of the bladder is uncertain. In our study, heterogeneous adjuvant, neoadjuvant chemotherapy and combination radio-chemotherapy regimens were performed because all the patients were received at advanced stages of disease. Patients with non-schistosomiasis-related SCC of the bladder have an unfavorable prognosis. The natural history of NBSCC of bladder is characterized by locoregional evolution while metastatic extension is rare ranging from 8% to 10%; which strongly distinguished NBSCC from transitional cell tumors. In the absence of effective therapy, locoregional failures of SCC of the bladder will continue to be the primary cause of death in these patients [4]. In our study, we notified more locoregional recurrence in patients treated by chemoradiation more than patients treated by surgery, yet we can't extract conclusions because patients receiving chemoradiation had tumors at advanced stage. | ||||||
|
Conclusion
| ||||||
|
In summary, primary squamous cell carcinoma (SCC) in the non-bilharzial bladder is a rare entity. It has a poor prognosis, and most patients die of locoregional failure. Local control is more important in the treatment approach. Most authors support cystectomy as the most appropriate treatment. | ||||||
|
Acknowledgements
| ||||||
|
Zineb bouchbika, Nadia benchakroun, Nezha tawfiq | ||||||
|
References
| ||||||
| ||||||
|
[HTML Abstract]
[PDF Full Text]
|
|
Author Contributions:
Fatima Safini – Substantial contributions to conception and design, Acquisition of data, Analysis and interpretation of data, Drafting the article, Revising it critically for important intellectual content, Final approval of the version to be published Hassan Jouhadi – Analysis and interpretation of data, Revising it critically for important intellectual content, Final approval of the version to be published Meriem Elbachiri – Analysis and interpretation of data, Revising it critically for important intellectual content, Final approval of the version to be published Souha Sahraoui – Analysis and interpretation of data, Revising it critically for important intellectual content, Final approval of the version to be published Abdellatif Benider – Analysis and interpretation of data, Revising it critically for important intellectual content, Final approval of the version to be published |
|
Guarantor of submission
The corresponding author is the guarantor of submission. |
|
Source of support
None |
|
Conflict of interest
Authors declare no conflict of interest. |
|
Copyright
© 2016 Fatima Safini et al. This article is distributed under the terms of Creative Commons Attribution License which permits unrestricted use, distribution and reproduction in any medium provided the original author(s) and original publisher are properly credited. Please see the copyright policy on the journal website for more information. |
|
|